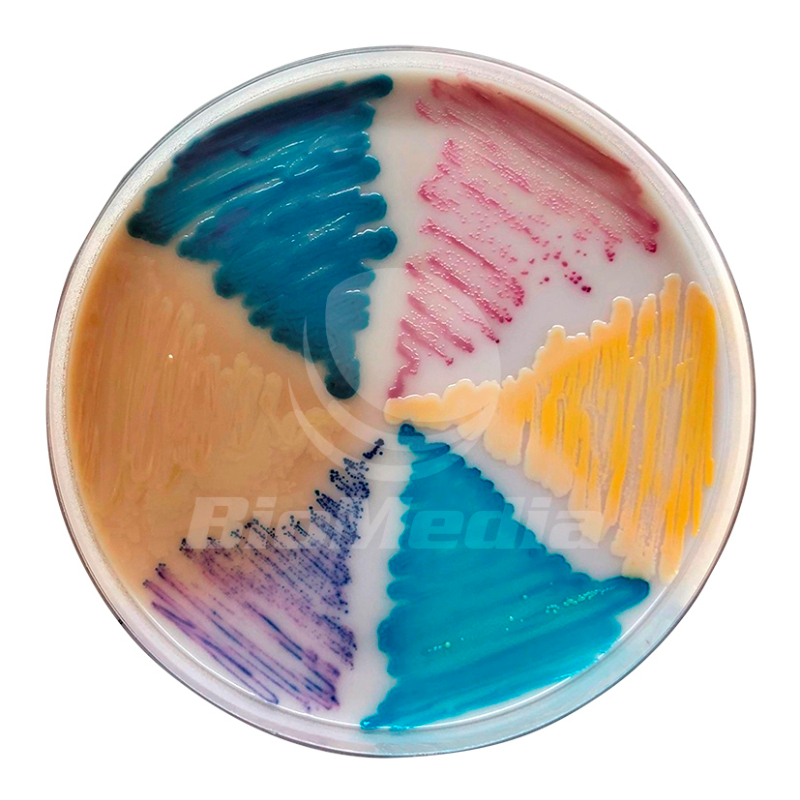

- Главная страница
- Партнёры
- Biomedia
Партнёры
Biomedia

Biomedia (Россия) — производитель готовых питательных сред, лидер по производству питательных сред для микробиологии в чашках Петри в России. Все питательные среды Biomedia имеют регистрационное удостоверение Росздравнадзора.
В компании ООО Biomedia функционирует система менеджмента качества, которая соответствует требованиям международного стандарта ISO 9001:2015 и государственного стандарта ГОСТ Р ИСО 9001‑2015.
Компания Хеликон, как официальный дистрибьютор Biomedia, предлагает под заказ кровяные и хромогенные среды, а также иные питательные среды для микробиологии.
За подробной информацией о товарах, ценах и сроках поставки обращайтесь к нашим специалистам по телефону 8 (800) 770‑71‑21 (звонки для всех абонентов на территории РФ бесплатны) или электронной почте mail@helicon.ru.

Интернет-магазин Хеликон
Подробнее ознакомиться с продукцией Компании Хеликон можно в Интернет-магазине
Возникли вопросы?
Пожалуйста, заполните форму, и наш менеджер ответит вам в течение 24 часов.
Задать вопрос



.jpg)